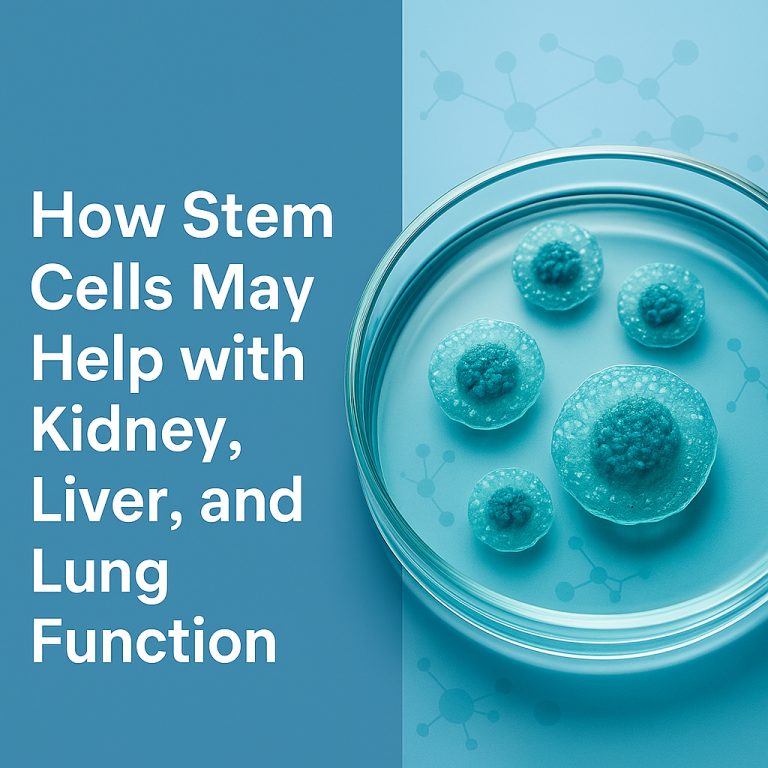
Petri dish with stem cells, representing regenerative therapy for kidney, liver, and lung health at Cellular Regeneration Clinic

Stem Cell Therapy for Aging Organs | CRC Tijuana
Stem Cell Therapy for Age‑Related Organ Decline (Heart, Liver, Kidney) As we age, many organs gradually lose function — the heart pumps less efficiently, the liver detoxifies more slowly, and kidneys filter toxins less effectively.